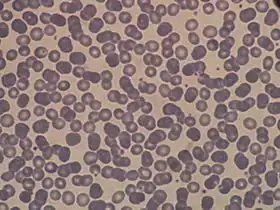

خون
نوعی بافت پیوندی متشکل از انواع سلول و ماده پلاسماست که در رگ ها جریان دارد.بدن برای زنده ماندن به خوراک و اکسیژن نیازمند است ولی فقط بودن غذا در معده و بودن اکسیژن در ششها کافی نیست، بلکه این دو باید به همه نقاط بدن برسند و خون این عمل یعنی رساندن آن مواد به همه بدن را برعهده دارد. خون در لولههایی به نام رگ جریان مییابد. قلب، خون را در رگها به جریان میاندازد.[1]

در حدود ۷ الی ۸ درصد وزن بدن را خون تشکیل میدهد و در انسان بالغ بهطور متوسط ۵ تا ۶ لیتر از حجم بدن را خون تشکیل میدهد.[2]
یک قطره خون به یک قطره جوهر قرمز میماند، ولی ساختارش به سادگی ساختار جوهر نیست. در حقیقت خون از سلول های مختلفی ساخته شده است که هر یک کار ویژه ای را انجام می دهند. قرمز دیده شدن رنگ خون به دلیل وجود گلبول های قرمز فراوان است. گلبولهای قرمز اکسیژن را در هموگلوبین خود به تمام نقاط بدن رسانده و نیاز اکسیژن سلول ها را تامین می کنند. قسمت مایع خون پلاسما نام دارد. قسمت عمده پلاسما را آب تشکیل می دهد. از وظایف پلاسما می توان تامین نیاز غذایی سلول های بدن و دفع مواد زائد که عمدتا کربن دی اکسید میباشد را نام برد.[1]
جزئیات
خون به صورت مایع است و کار اصلی آن رساندن اکسیژن و موادّ تغذیهکننده مانند گلوکز و سازنده به بافتها و کمک به دفع موادّ زائد (همچون کربن دیاکسید و اسید لاکتیک) از بافتهای بدن و دفاع در برابر میکروارگانیسمها است. این مایع بهوسیلهٔ پمپاژ قلب (یا ساختاری همانند) توسط رگها، به تمام قسمتهای بدن منتقل میشود. خون هم یک شاره و هم یک نوع بافت، محسوب میشود و بافت نامیده شدن آن، از آن روست که شامل مجموعهای از یاختههای ویژه است که وظایف و اعمال خاصی را بهانجام میرسانند. این یاختهها در مادهٔ میانیاختهای و زمینهای مایعی به نام پلاسما شناورند که به خون حالت شاره میبخشد.[3] به دانش بررسی خون، خونشناسی گفته میشود.
فعالیتها

سبز = heme groups
قرمز و آبی = protein subunits
- اکسیژن رسانی به سلولها، که توسط هموگلوبین انجام میشود.
- انتقال مواد مغذی همچون اسیدهای آمینه، گلوکز و اسیدهای چرب.
- برداشت مواد زاید همچون دیاکسید کربن، اوره و اسید لاکتیک از بدن.
- عملکردهای ایمنی با حمل گلبولهای سفید و کشف مواد خارجی با استفاده از آنتیبادیهای محلول در آن.
- انعقاد خون که یکی از عملکردهای خود بهبودی بدن است.
- نقش پیام رسانی که با انتقال هورمونها و پیام دهی در آسیب بافتی انجام میشود.
- تنظیم پیاچ بدن
- تنظیم دمای بدن
- فعالیتهای هیدرولیک.[4]
- گروه خونی O، دهنده عمومی و AB، گیرنده عموم است.
- برای پیوند اعضای بدن مانند پیوند کلیه گروه خونی و فاکتورهای دیگر خون مورد بررسی قرار میگیرد.
خون یک بافت همبند است. در شکل RBCها گلبولهای قرمز را میبینیم. پلاکتها که به صورت دانههای ریزی است.
گلبولهای سفید ( WBC ) خون که لوکوسیتها نامیده میشوند شامل:
- آگرانولوسیتها
- مونوسیتها: لوبیایی شکل
- لنفوسیتها: هسته بسیار درشت و سیتو پلاسم نوار باریکی در اطرافش
گرانولوسیتها خود به سه دسته ذیل تقسیم میشوند:
- نوتروفیل:هسته چند قسمتی
- بازوفیل: هسته گرانولیسیتی به صورت دانه دار
- ائوزینوفیل:هسته دو قسمتی
ترکیبات

Left tube: after standing, the RBCs have settled at the bottom of the tube.
Right tube: contains freshly drawn blood.
پلاسما
پلاسما ۵۵ درصد خون را تشکیل میدهد. مایعی است که ۹۱ درصد آن را آب، ۷ درصد آن را پروتئینها، یک درصد آن را املاح معدنی و یک درصد بقیه را ویتامینها، مواد قندی و مواد لیپیدی، هورمونها و اسیدهای آمینه تشکیل میدهند. پروتئینهای عمده پلاسما آلبومین پروتئین اصلی خون میباشد که به وسیلهٔ کبد ساخته میشود و مهمترین وظیفه آن حفظ فشار اسمزی خون میباشد. در ضمن در حمل مواد غیرمعمول در آب، نظیر اسیدهای چرب آزاد نقش عمدهای دارد. فیبرینوژن، پروتئینی است که در کبد سنتز میشود؛ و پس از تبدیل شدن به فیبرین در انعقاد خون شرکت میکند. گلوبینها از نظر وزن مولکولی به سه دسته گاما گلبولینها، بتا گلبولینها و آلفا گلبولینها تقسیم میشوند؛ که مهمترین آنها گاما گلبولینها هستند که به آنتیبادیها یا ایمونو گلبولینها نیز مشهورند.
مراحل خونسازی
الف)قبل تولد ب)بعد از تولد
قبل از تولد
۱. خونسازی اولیه یا primitive: توسط سلولهای مزانشیم در کیسه زرد شکل میگیرد این خونسازی در ماه اول، هفته سوم و روز نوزدهم حاملگی اتفاق میافتد و پایان آن در ماه سوم حاملگی است.
۲. خونسازی قطعی یا definitive: در A.G.M آغاز میشود و سپس سلولهای بنیادی به کبد و طحال جنینی مهاجرت میکنند تا در آنجا تولید خون کنند.از هفته شش جنینی در کبد آغاز و پایان ان یک هفته بعد از تولد است.
بعد از تولد
مغز استخوان آخرین مرحله خونسازی است و تا پایان عمر ادامه دارد. شروع خونسازی در این مرحله از ماه پنجم حاملگی تا پایان عمر است. منابع (هنری _دیویدسون) و (هافبراند)
منابع
| مجموعهای از گفتاوردهای مربوط به خون در ویکیگفتاورد موجود است. |
| در ویکیانبار پروندههایی دربارهٔ خون موجود است. |
- مدخل خون در: پارکر، برتا موریس: فرهنگنامه پارکر. جلد هفتم. ترجمه و تنظیم و نگارش زیر نظر: رضا اقصی. شرکت سهامی کتابهای جیبی. با همکاری مؤسسه انتشارات فرانکلین. چاپ اول. ۱۳۴۶ خورشیدی.
- «خون چیست؟». بایگانیشده از اصلی در ۸ ژانویه ۲۰۱۲. دریافتشده در ۱۵ تیر ۱۳۸۷.
-
- "خون". دانشنامه بریتانیکا (به قلم سی. کولارد کانلی و رابرت اس. شوارتز). 2008. Retrieved 28 June 2008.
- Blood. (2008, June 26). In Wikipedia, The Free Encyclopedia. Retrieved 20:32, June 29, 2008, from http://en.wikipedia.org/w/index.php?title=Blood&oldid=221848879
